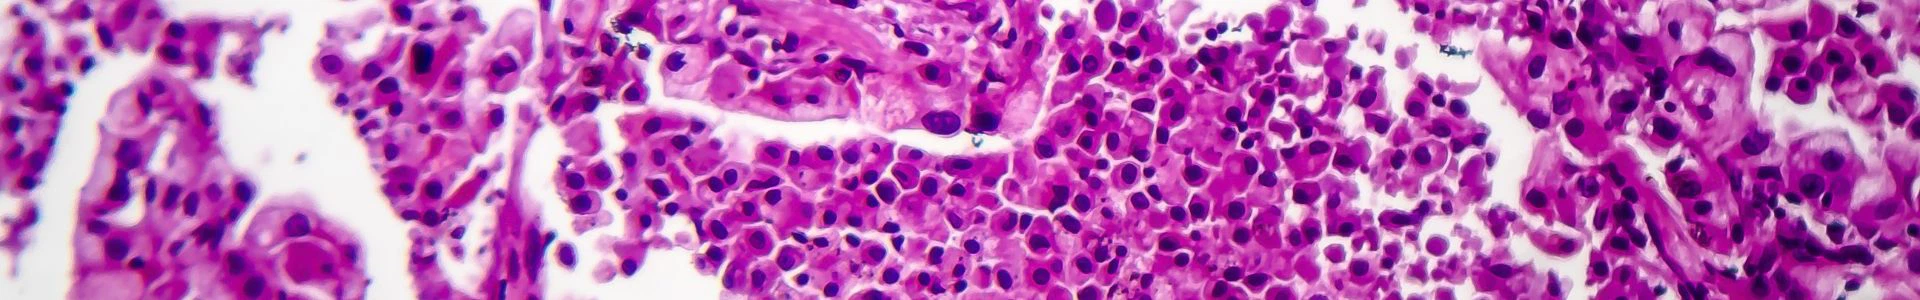
Banner

Módulo de volumen pulmonar CT
Plataforma de investigación para la investigación de enfermedades en respirología
El área de enfermedades de Respirología se centra en el estudio y tratamiento de las enfermedades que afectan al sistema respiratorio. Este campo abarca una amplia gama de afecciones que afectan los pulmones y las vías respiratorias, incluidas enfermedades agudas y crónicas. La investigación en respirología tiene como objetivo comprender la fisiopatología de los trastornos respiratorios, mejorar las técnicas de diagnóstico y desarrollar tratamientos y medidas preventivas eficaces. Utilizando modelos animales avanzados, ensayos clínicos y tecnologías de vanguardia, los investigadores exploran los mecanismos de las enfermedades pulmonares y evalúan nuevos enfoques terapéuticos. Un enfoque integral es esencial para mejorar la atención al paciente, mejorar los resultados del tratamiento y mejorar la salud respiratoria.
Por qué utilizar NHP para el modelado de investigación de enfermedades en respirología
El uso de primates no humanos (NHP) en la investigación de enfermedades respirológicas es muy ventajoso debido a su gran parecido fisiológico e inmunológico con los humanos. Esta similitud garantiza que los datos de los modelos NHP sean altamente traducibles, lo que mejora la precisión de los hallazgos preclínicos y respalda el desarrollo de tratamientos eficaces para enfermedades respiratorias como el asma, la EPOC y la fibrosis pulmonar. La compleja anatomía pulmonar y el sistema inmunológico de los NHP permiten un estudio detallado y confiable de los mecanismos de la enfermedad y las intervenciones terapéuticas, lo que los hace indispensables para mejorar la salud respiratoria humana.
Similitud fisiológica
Los NHP tienen estructuras pulmonares y funciones respiratorias que reflejan fielmente las de los humanos, lo que los hace muy relevantes para estudiar las enfermedades respiratorias humanas.
Semejanza inmunológica
Las respuestas inmunes de los NHP son notablemente similares a las de los humanos, lo que permite modelar con precisión los mecanismos de las enfermedades respiratorias y las interacciones inmunes.
Traducibilidad
Los datos obtenidos de los modelos NHP son altamente traducibles a las condiciones humanas, lo que mejora el valor predictivo de la investigación preclínica y el desarrollo de tratamientos eficaces para enfermedades como el asma, la EPOC y la fibrosis pulmonar.
Modelado de enfermedades complejas
La sofisticada anatomía pulmonar y el sistema inmunológico de los NHP permiten el estudio detallado de mecanismos complejos de enfermedades respiratorias e intervenciones terapéuticas, proporcionando información sólida sobre la progresión de la enfermedad y la eficacia del tratamiento.
Resultados confiables
El uso de NHP garantiza hallazgos preclínicos sólidos y confiables, que son fundamentales para mejorar la salud humana y acelerar el desarrollo de nuevas terapias para enfermedades respiratorias.
Plataforma Superior de Investigación en Respirología de Prisys
La Plataforma de Tecnología Respiratoria de Prisys Biotech está diseñada para abordar diversas afecciones respiratorias a través de modelos de investigación y tecnologías de entrega innovadores. Esta plataforma apoya el desarrollo de nuevos tratamientos mediante la simulación de enfermedades respiratorias humanas enModelos NHP , asegurando un alto valor traslacional:
Entrega de pulmones y vías respiratorias
Las técnicas de aerosol intratraqueal, destilación pulmonar y muestreo de las vías respiratorias se utilizan para administrar medicamentos directamente al sistema respiratorio.
Destilación pulmonar
Las técnicas de destilación pulmonar permiten la administración de fármacos en forma líquida directamente al tejido pulmonar, mejorando la absorción y la eficacia.
Muestreo de vías respiratorias
Las técnicas de muestreo de las vías respiratorias se utilizan para recolectar muestras del tracto respiratorio, lo que proporciona datos valiosos para la investigación respiratoria y el desarrollo de fármacos.
Modelos de enfermedades de respirología
|
Enfermedad Pulmonar Obstructiva Crónica (EPOC) : Bronquitis crónica Enfisema |
Asma: Asma no alérgica Asma inducida por el ejercicio |
Enfermedades pulmonares intersticiales (EPI): Fibrosis pulmonar idiopática (FPI) sarcoidosis Neumonitis por hipersensibilidad |
|
Enfermedades respiratorias infecciosas: Neumonía (bacteriana, viral, fúngica) Tuberculosis (TB) Influenza COVID-19 |
Enfermedades vasculares pulmonares: Hipertensión pulmonar Embolia pulmonar |
Cáncer de pulmón: Cáncer de pulmón de células no pequeñas (NSCLC) Cáncer de pulmón de células pequeñas (CPCP) mesotelioma |
Preguntas frecuentes

¿Qué hace que los primates no humanos (NHP) sean ideales para la investigación de enfermedades respirológicas en Prisys?
Similitud fisiológica e inmunológica: Los NHP tienen sistemas respiratorios y respuestas inmunes que se parecen mucho a las de los humanos. Esta similitud garantiza que los resultados de la investigación sean muy relevantes y traducibles a las condiciones humanas, lo que mejora la precisión de los estudios preclínicos.
¿Cómo mejora Prisys el valor traslacional de la investigación en respirología?
Datos altamente traducibles: El uso de modelos NHP en Prisys genera datos que reflejan fielmente las respuestas humanas, mejorando así el valor predictivo de la investigación preclínica. Esto respalda el desarrollo de tratamientos eficaces para enfermedades respiratorias como el asma, la EPOC y la fibrosis pulmonar.
¿Qué modelos de enfermedades respiratorias avanzadas se utilizan en Prisys?
Modelos integrales de enfermedades: Prisys emplea modelos como enfermedades atópicas, neumonía inflamatoria, fibrosis pulmonar idiopática (FPI) y enfermedad pulmonar obstructiva crónica (EPOC) en monos cynomolgus. Estos modelos replican aspectos clave de las enfermedades respiratorias humanas, lo que permite un estudio detallado de los mecanismos de la enfermedad y las intervenciones terapéuticas.
¿Cómo apoyan las plataformas y técnicas de investigación de Prisys la investigación de enfermedades respiratorias?
Plataformas de investigación innovadoras: La plataforma de tecnología respiratoria de Prisys incluye metodologías avanzadas como administración de aerosol intratraqueal, destilación pulmonar y técnicas de muestreo de las vías respiratorias. Estas tecnologías mejoran la administración de medicamentos y la recopilación de datos, lo que garantiza un alto valor traslacional y respalda el desarrollo de nuevos tratamientos para enfermedades respiratorias.
Contáctenos para más información